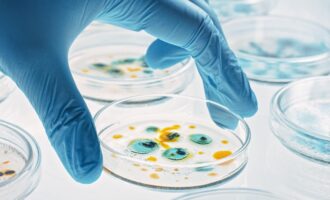
هوش مصنوعی و آنتی‌بیوتیک

باکتری
آخرین مطالب
-
محققان: بوسیدن میتواند تا ۸۰ میلیون باکتری را بین دو نفر منتقل کند
به گفته محققان هلندی، بوسیدن به مدت 10 ثانیه میتواند 80 میلیون باکتری را بین 2 نفر منتقل کند.
![بوسه و باکتری]() ۲۹ دی ۱۴۰۳
۲۹ دی ۱۴۰۳
-
محققان: موجودات و باکتریهای آینهای میتوانند در آینده برای انسان کشنده باشند
محققان میگویند در یک دهه آینده احتمالاً باکتریهای آینهای در آزمایشگاهها ایجاد میشوند و برای انسان خطرناک خواهند بود.
![باکتریهای آینهای]() ۳ دی ۱۴۰۳
۳ دی ۱۴۰۳
-
مطالعه جدید دانشمندان: دوستان صمیمی حتی باکتری روده مشابهی دارند
شباهت بین شما و دوستانتان می تواند فراتر از خصوصیات اخلاقی و شخصیتی باشد. براساس مطالعه ای جدید این شباهت می تواند باکتری های پوشاننده ...
![]() ۹ آذر ۱۴۰۳
۹ آذر ۱۴۰۳
-
مطالعه جدید: باکتریهای داخل دهان به یک روش عجیب و نادر تولیدمثل میکنند
شکافت چندتایی باکتری سی. ماتروکوتی توضیح میدهد که چرا پلاکهای دندان چند ساعت بعد از مسواک زدن دوباره ظاهر میشوند.
![تولیدمثل باکتری های پلاک دندان]() ۱۵ شهریور ۱۴۰۳
۱۵ شهریور ۱۴۰۳
-
این جانداران ریز از ژن باکتریها برای تولید آنتیبیوتیک و مبارزه با بیماریها استفاده میکنند
دانشمندان عقیده دارند که موجوداتی موسوم به «چرخانتباران» میتوانند راهی برای تولید آنتیبیوتیکهای ایمنتر برای انسانها و حیوانات به ما نشان دهند.
![چرخان تباران]() ۳۱ تیر ۱۴۰۳
۳۱ تیر ۱۴۰۳
-
دستاورد محققان: باتری جدیدی که انرژی خود را از درون خاک تأمین میکند
این باتریها میتوانند در تأمین انرژی ارزان و پاک در کشاورزی سودمند واقع شود.
![باتری و باکتری]() ۳۰ خرداد ۱۴۰۳
۳۰ خرداد ۱۴۰۳
-
کشف باکتریهای خونآشام مرگباری که جذب خون میشوند
در آزمایشهایی که برای مطالعه انجام شد، کمتر از یک دقیقه طول کشید تا باکتریهای خونآشام متوجه شوند که خون در آن نزدیکی است.
![]() ۳۰ فروردین ۱۴۰۳
۳۰ فروردین ۱۴۰۳
-
دستاورد محققان: هوش مصنوعی مولدی که میتواند آنتیبیوتیکهای جدید طراحی کند
هوش مصنوعی مولد «SyntheMol» میتواند آنتیبیوتیکهای جدیدی برای مقابله با باکتریهای خطرناک طراحی کند.
![هوش مصنوعی و آنتیبیوتیک]() ۵ فروردین ۱۴۰۳
۵ فروردین ۱۴۰۳
-
محقق MIT توانست بازی Doom را با باکتریهای روده اجرا کند!
بازی محبوب Doom روی پلتفرمهای عجیب و مختلف زیادی اجرا شده، و حالا یک محقق بهسراغ اجرای آن روی باکتریهای روده رفته است.
![اجرای بازی Doom با باکتری روده]() ۱۶ بهمن ۱۴۰۲
۱۶ بهمن ۱۴۰۲
-
کشف محققان با کمک هوش مصنوعی: ترکیباتی که باکتریهای مقاوم به دارو را از بین میبرند
باکتریهای مقاوم به آنتیبیوتیک هرساله باعث مرگ میلیونها نفر میشوند؛ حالا هوش مصنوعی ترکیباتی را پیدا کرده است که میتواند به کمک ما بیاید.
![باکتری]() ۲ دی ۱۴۰۲
۲ دی ۱۴۰۲
-
دانشمندان با مهندسی باکتریها، دو محصول ارزشمند از فیبر گیاهی تولید میکنند
اکنون محققان دانشگاه ویسکانسین-مدیسون باکتریهایی را مهندسی کردهاند که میتوانند همزمان دو محصول شیمیایی را از الیاف گیاهی کممصرف تولید کند.
![]() ۱ دی ۱۴۰۲
۱ دی ۱۴۰۲
-
مطالعه جدید: برخی از باکتریهای روده میتوانند به بهبود سلامت روان کمک کنند
باکتری لاکتوباسیلوس با کنترل پروتئینهای سیستم ایمنی واکنشهای مغز را در محیطهای استرسزا تنظیم میکند.
![نقش باکتری های روده در سلامت روان]() ۱۰ آذر ۱۴۰۲
۱۰ آذر ۱۴۰۲
-
برای اولینبار ارتباط بین میوهها، سبزیجات و میکروبیوم در تحقیق جدیدی تأیید شد
به گفته دانشمندان، باکتریهای مربوط به میوه و سبزیجات بهطور متوسط 2.2 درصد از تنوع کل باکتریهای ما را تشکیل میدهد.
![میکروبیوم]() ۶ آبان ۱۴۰۲
۶ آبان ۱۴۰۲
-
دانشمندان با مهندسی باکتریها، تومورهای سرطانی را در موشها نابود کردند
پژوهشگران دانشگاه آکسفورد توانستهاند با روشی آسان و بدون التهاب درمانی برای مبارزه با سرطان در موشها پیدا کنند.
![باکتری Staphylococcus epidermidis]() ۲۶ فروردین ۱۴۰۲
۲۶ فروردین ۱۴۰۲
-
محققان: قرص طلا میتواند درمانی برای مقابله با باکتریهای مقاوم به آنتیبیوتیک باشد
با افزایش مقاومت باکتریها به داروهای آنتیبیوتیک، دانشمندان به سراغ طلا رفتهاند تا راهی برای مقابله با این بیماریها پیدا کنند.
![]() ۲۲ فروردین ۱۴۰۲
۲۲ فروردین ۱۴۰۲
-
کشف جدید علمی: محققان آنزیم باکتریایی را شناسایی کردهاند که میتواند از هوا، برق تولید کند
آنزیم یافتشده در یک باکتری خاکی توسط دانشمندان، پتانسیل تولید برق از هوا و استفاده بهعنوان باتری زیستی را دارد.
![تولید برق از هوا]() ۱۹ اسفند ۱۴۰۱
۱۹ اسفند ۱۴۰۱
-
دانشمندان یک مولکول ضدقارچ جدید را بهخاطر اثربخشی بالا، با الهام از «کیانو ریوز» نامگذاری کردند
محققان میگویند یک نوع خاص از باکتریها مادهای را تولید میکند که کشنده قارچها بوده و ازاینرو، نام خود را از «کیانو ریوز» گرفته است.
![ماده ضدقارچی کیانو]() ۲۶ بهمن ۱۴۰۱
۲۶ بهمن ۱۴۰۱
-
دستاورد دانشمندان ژاپنی: طراحی کوچکترین باکتری مصنوعی جهان که میتواند بهتنهایی حرکت کند
دانشمندان ژاپنی موفق شدهاند کوچکترین شکل حیات مصنوعی، یعنی نوعی باکتری را طراحی کنند که بهتنهایی حرکت میکند.
![باکتری مصنوعی]() ۱۸ آذر ۱۴۰۱
۱۸ آذر ۱۴۰۱
-
پژوهشگران: ویروسها با تحت نظر گرفتن میزبان خود، درباره زمان حمله تصمیمگیری میکنند
مطالعهای تازه نشان میدهد که ویروسها احتمالا میزبان خود را زیر نظر گرفته و مطابق با شرایط تصمیم میگیرند که چه فعالیتی انجام دهند.
![]() ۱۹ مهر ۱۴۰۱
۱۹ مهر ۱۴۰۱
-
حل یک معمای 50 ساله؛ محققان بالاخره فهمیدند باکتریها چگونه حرکت میکنند
محققان در مطالعات جدید خود با جزئیاتی در سطح اتمی دریافتهاند که باکتریها چگونه قابلیت حرکت کردن را دارند.
![باکتری]() ۶ مهر ۱۴۰۱
۶ مهر ۱۴۰۱

همچنین میتوانید جهت آگاهی از آخرین اخبار در حوزه تکنولوژی و اطلاع از بروزرسانی دیجیاتو مارا در شبکههای اجتماعی زیر نیز دنبال کنید. خوشحالیم که همراه ما هستید.